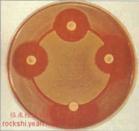
葡萄球菌性肺炎

葡萄球菌性肺炎
葡萄球菌性肺炎
葡萄球菌性肺炎症狀和體徵
葡萄球菌性肺炎儘管來勢兇猛,但有些病情並不嚴重,個別病程較為緩慢,有時形成慢性肺炎或慢性肺膿腫.臨床症狀與肺炎球菌性肺炎的臨床症狀相似.葡萄球菌性肺炎的特點是容易引起反覆寒戰,組織壞死伴膿腫形成和肺囊腫(大多見於嬰幼兒);病情急且有明顯衰竭.膿胸較常見.金黃色葡萄球菌主要存在於胸廓切開後的膿胸或胸壁外傷後血胸使用引流的膿胸中.
診斷
病人咳出痰液中發現有金黃色葡萄球菌可懷疑本病,確定診斷要從血液培養,膿胸的膿液或氣管或胸腔抽出物中發現金黃色葡萄球菌.金黃色葡萄球菌與肺炎球菌不同,較易培養,因此假陰性不多見.最常見的X線異常為支氣管肺炎伴或不伴膿腫形成或胸腔積液;大葉性實變不多見.肺氣囊強烈提示為葡萄球菌感染.栓塞性葡萄球菌性肺炎的特徵是在不相鄰的部位有多發性浸潤,浸潤易形成空洞,這些現象表示病因來源於血管內(如右側心內膜炎或膿毒性血栓性靜脈炎).
預後和治療
一般病死率為30%~40%.造成死亡的部分原因是大多數病人伴有嚴重的合併症.然而有些成年人本來很健康,但在流感後得了這種肺炎,病情發展快,最後導致死亡.抗生素療效慢,恢復期長.
大多數金黃色葡萄球菌產生青黴素酶,且對甲氧西林的耐藥性正在增加.一般主張用一種能抗青黴素酶的青黴素(如苯唑西林或萘夫西林2g,靜脈注射,每4~6小時1次.另一類主要藥物是頭孢菌素:常用的為頭孢噻吩或頭孢孟多2g,靜脈注射,每4~6小時1次,頭孢唑啉0.5~1.0g,靜脈注射,每8小時1次,或頭孢呋辛750mg,靜脈注射,每6~8小時1次.第三代頭孢菌素的效果不如第一代或第二代製劑.林可黴素600mg靜脈注射,每6~8小時1次對90%~95%菌株有效.
一般認為,對甲氧西林耐藥的菌株,對所有β-內醯胺抗生素均有抵抗力.在許多醫院,此類菌株占醫院獲得性葡萄球菌的30%~40%,而僅占社區獲得性感染的5%.如懷疑或經體外藥敏試驗證明對甲氧西林耐藥,一般用萬古黴素.常用劑量為1g靜脈注射,每12小時1次;有腎功能衰竭時適當調整用量.

